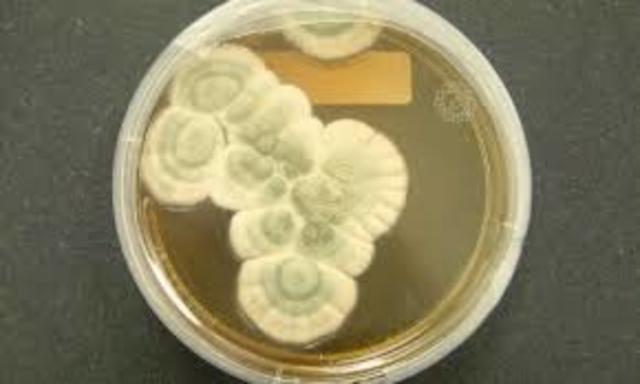
ALEXANDER FLEMMING

-
Con su invento (microscopio), permitió el descubrimiento de hongos microscópicos.
-
Descubrió la causa (Beauveria bassiana) de la enfermedad del gusano de seda (Muscardina).
-
Estudió el hongo favus.
-
Describió en Argentina el primer caso coccidioidomicosis.
-
Padre de la micología moderna. Introdujo el tratamiento para la dermatofitosis en el cuero cabelludo.
-
En el Canal de Panamá describió la Histoplamosis.
-
Habla sobre la inmunología de las micosis.
-
Descubre la primera sustancia antibiótica del mundo: Penicilina.
-
Determina las bases de la nomenclatura de hongos de acuerdo a su forma de reproducción.
-
Postula la clasificación de los hongos en el reino "fungi".
Plan projects on a visual timeline
Map milestones, phases, deadlines, and key events in one place so the sequence is easier to see and share. Timetoast is a timeline maker for work, school, research, and stories.